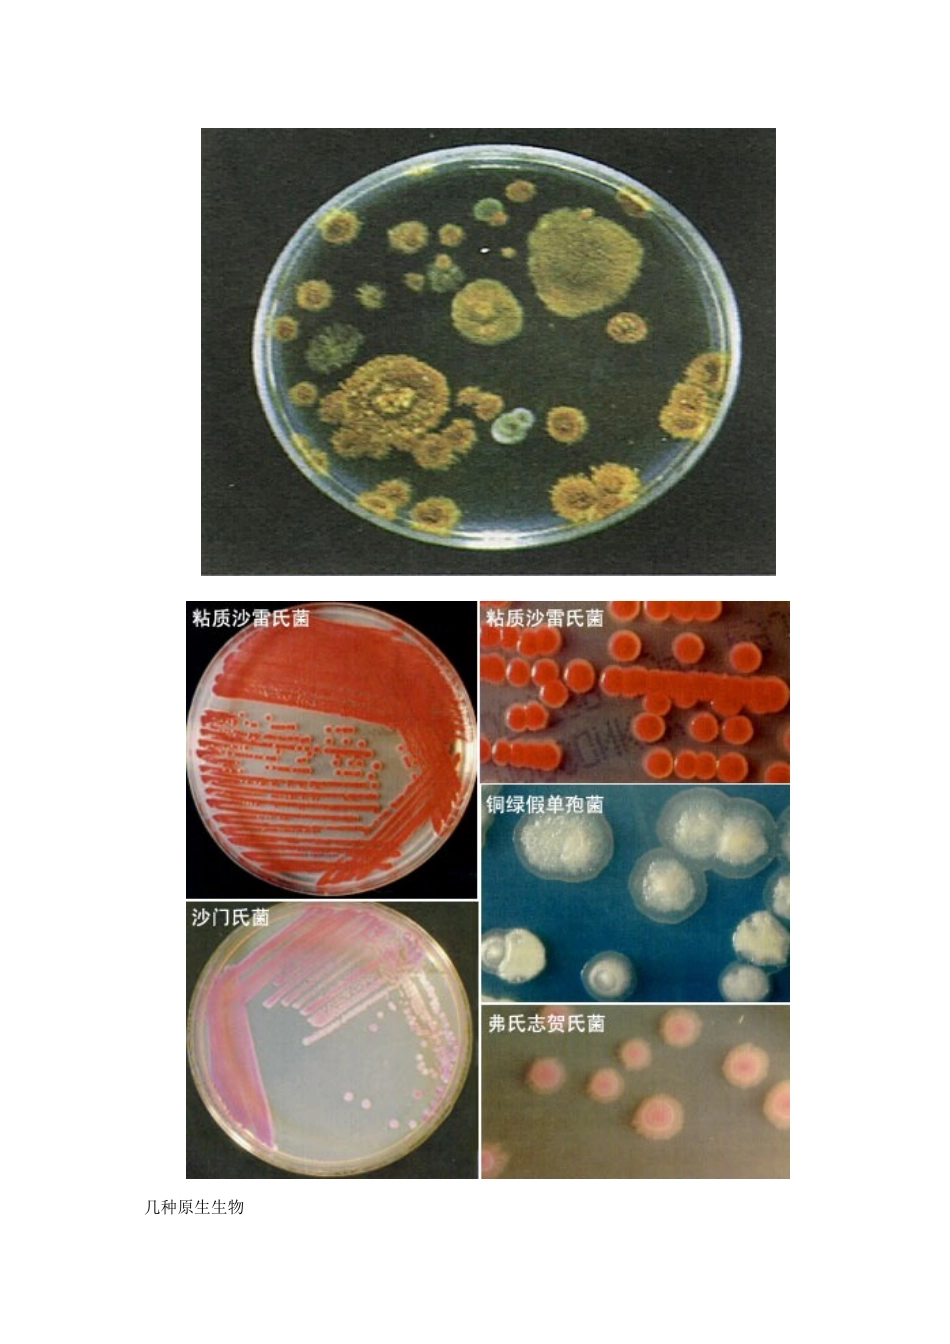
高中生物 同步资料 1.2_第2页

寿命最长的细胞 细胞是具有生命的机体结构和功能单位
人体所含细胞数量的多少,取决于个体的大小,而且细胞数量几乎每一瞬间都有变化
细胞是在不断生长繁殖之中,所以存在细胞寿命长短问题,这种长短,各类细胞差别也很大,如很多人知道的红细胞寿命大约 120 天,而神经细胞的数量,出生时有多少以后就有多少,不能增加,可见神经细胞的寿命最长
俗话说:“万两黄金易尽,一线江河永存”,脑细胞死一个就少一个、衰老便不由人愿了,可见“笑一笑十年少,愁一愁白了头”是有些道理的
体内最大的细胞 体内最大的细胞有各种说法:(1)按细胞直径而言,要数卵细胞,其直径约 200 微米,即 0
2 毫米(1 微米=1/1000 毫米)
(2)以细胞长度来说,当之为骨骼肌细胞,长的可超过 4 厘米
(3)而以细胞突出的长度来划分,当之无愧的是神经细胞(也称神经元)
神经元的轴突长的可达 1 米以上
故神经元可称之为体内最大的细胞了
它们的活动受机体神经体液因素的调节
菌落:菌落:单个或者少数细菌在固体培养基上大量繁殖时,会形成一个肉眼可单个或者少数细菌在固体培养基上大量繁殖时,会形成一个肉眼可见的、具有一定形态结构的子细胞群体
见的、具有一定形态结构的子细胞群体
无鞭毛的球菌:菌落较小较厚、边缘整齐
有鞭毛的细菌:菌落大而扁平、边缘波状或锯齿状
几种原生生物发菜发菜,国家Ⅰ级重点保护野生植物
发菜为藻类植物门植物发菜的藻体
发菜贴在于荒漠植物的下面,因其 形如乱发,颜色乌黑,得名“发菜”,也被人称之为“地毛”
是一种极名 贵的食物
发菜每百克于品含蛋白质 20
3 克,碳水化合物 56 克,钙高达 2560 毫克,铁 20 毫克,均高于猪、牛、羊肉类及蛋类
它突出特点是脂肪含量极少
发菜性味甘、寒
具有清热消滞、软坚化痰、理肠除垢的功效
发菜还具有降血压
调节神经等多种作用,是高血压,冠心病、高血脂病患者的